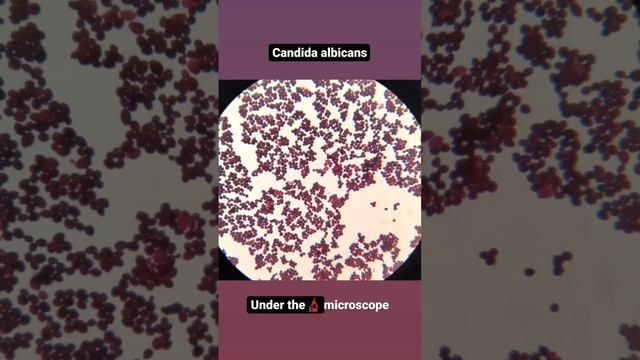

Кандида альбиканс у детей
Союзкомплект ухта
Значение слова благой
Как из нижнего новгорода доехать до городца
Банки в новороссийске вклады физических лиц
Последствия изменения видового состава экосистемы
Нормы веса в 40 лет
Как победить кушту в споре
Хорошие гитары 12 струнные
Матч года тренера
Что входит в кэшбэк транспорт
Астрал франшиза
Магазин яблоко в иркутске
Принято решение не выплачивать дивиденды
Кандида альбиканс у детей 114 фото